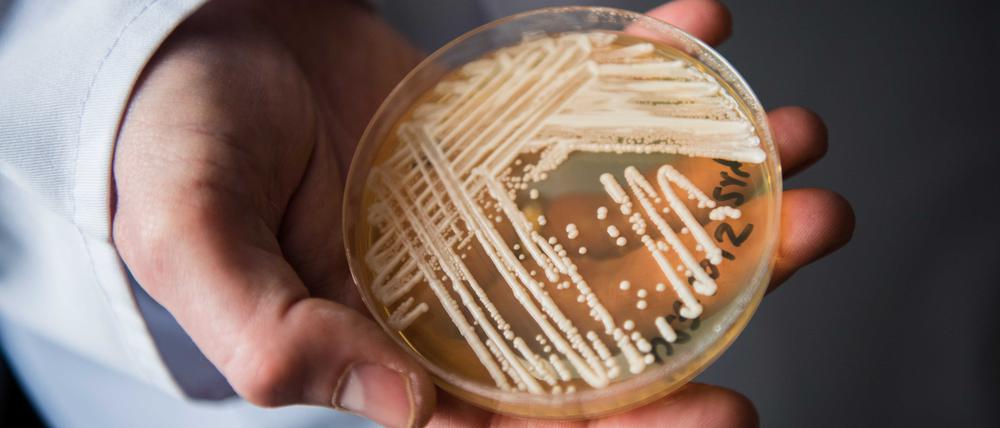
Candida auris in einer Kulturschale.

© dpa/Nicolas Armer
Zucker gegen Krankenhauskeim Candida: Potsdamer Forscher wollen Impfstoff gegen tödliche Hefen entwickeln
Angriff von drei Seiten: Forscher wollen aggressive Candida-Pilze mit Impfung, Medikamenten und Diagnostik bekämpfen. Komplexe Zuckermoleküle sollen dabei helfen.
Stand:
Brot, Bier, Geburtstagskuchen – Hefe klingt nach Gemütlichkeit. Doch manche Hefepilze sind echte Killer. Die Keime aus der Gattung Candida machen sich weltweit in Krankenhäusern breit, zuletzt auch an der Berliner Charité.
Ein Forschungsteam aus Potsdam ist dabei, gegen die Pilze eine Impfung und Diagnose-Tests zu entwickeln, erklärt es nun im Fachblatt „Proceedings of the National Academy of Sciences“.
Schlüssel dazu sind Zucker, genauer: verzweigte Ketten aus Zuckermolekülen auf der Außenseite des Pilzes. „Das sind die ersten Strukturen, die unser Immunsystem erfasst – gewissermaßen der Fingerabdruck des Erregers“, sagt Peter H. Seeberger, Direktor am Max-Planck-Institut für Kolloid- und Grenzflächenforschung.
Seebergers Abteilung ist darauf spezialisiert, solche komplexen Zuckerstrukturen chemisch herzustellen. Sein Team testete nun, wie Patientenblut und Mäuse auf verschiedene Arten dieser Moleküle reagierte und prüfte besonders charakteristische Zuckerkombinationen der jeweiligen Pilzarten. „Wir haben verzweigte Zuckerstrukturen gefunden, die spezifisch für die Immunantwort gegen bestimmte Candida-Subspezies war“, sagt die Biochemikerin Emelie Reuber.
Für einen Impfstoff müssen die Zucker, die jeweils typisch sind für krankmachende Pilze, an ein Eiweiß-Molekül gekoppelt werden. Im Körper lösen diese sogenannten Glykokonjugat-Impstoffe die gewünschte Reaktion des Immunsystems aus, die gegen künftige Infektionen wappnet. Als Vorbild dienen Impfstoffe gegen Bakterien wie Pneumokokken, die ebenfalls auf Zuckern basieren.
Ein wachsendes Problem
Die Bedrohung durch aggressive Pilzinfektionen wird immer größer: Fast vier Millionen Menschen pro Jahr kosten sie das Leben. Die Weltgesundheitsorganisation WHO hat dem Candida-Pilz dabei eine vorrangige Bedrohung eingeräumt. Gelangt er in die Blutbahn, kann es schnell lebensbedrohlich werden.
Gibt es einen Candida-Ausbruch, ist der Erreger zudem schwer wieder zu beseitigen. Er setzt sich auf den Oberflächen von medizinischen Geräten oder Schläuchen fest und bildet dort Schichten, die gegen Pilzbekämpfungsmittel unempfindlich sind. Manche Stämme haben zudem Resistenzen gegen bestimmte Wirkstoffe entwickelt.
Von dem Ausbruch an der Berliner Charité im Juni 2025 war nach Angaben der Klinik eine zweistellige Zahl an Patienten betroffen. Diese mussten isoliert werden. Ausgegangen war er von einem Patienten, der den Erreger Candida auris (auch genannt: Candidozyma auris) von einem Auslandsaufenthalt mitgebracht hatte.
Die Hürden sind hoch
Kann aber eine Impfung in der Praxis tatsächlich helfen? Schließlich sind besonders Personen mit eingeschränkten Immunsystem von den Infektionen betroffen. Reuber sagt, diesen Patienten könnten Injektionen von Antikörpern helfen. Diese Moleküle heften sich an die Zuckerstrukturen der Pilzzellen, bedecken sie so und machen es für das Immunsystem leichter erkennbar. Auch daran arbeiten das Team um Seeberger momentan.

© dpa/Nicolas Armer
Auf dem Weg zur Marktreife gibt es noch ein paar Stolpersteine. So wären die Potsdamer Impfstoffe die ersten gegen einen Pilz überhaupt. Wären die Hürden für eine behördliche Zulassung nicht besonders hoch? „Deswegen nutzen wir etwa Trägermoleküle, die schon in der Klinik sind“, sagt Reuber. Davon erhoffen sie und ihre Kollegen sich „eine gewisse Beschleunigung“.
Außerdem helfe es bei der Finanzierung, dass die WHO Pilzinfektionen kürzlich besonders hervorgehoben hat, indem sie eine Liste der bedrohlichsten Keime vorlegte, sagt Reuber: „Jetzt gibt es viel mehr Geld, das in die Forschung fließt.“ Ob sie selbst schon mit Industriepartnern an klinischen Versuchen arbeitet, wollte die Forscherin allerdings nichts verraten.
Und als Drittes forscht das Team an einem Schnelltest, der wie ein Corona- oder Schwangerschaftstest funktioniert. Derzeit müssen Kliniken Abstriche von Patienten entnehmen und mehrere Tage kultivieren. Der Schnelltest könnte Ergebnisse nach Minuten liefern. Vom fertigen Produkt sei man noch recht weit entfernt, gibt Reuber zu, hier sei man noch „am allerersten Protoypen“.
- showPaywall:
- false
- isSubscriber:
- false
- isPaid: